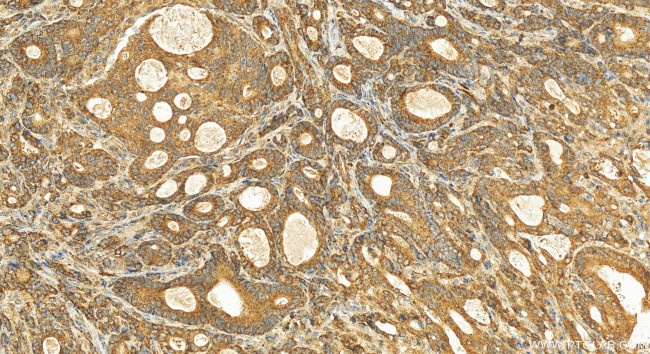
MICU2 Antibody in Immunohistochemistry (Paraffin) (IHC (P))

Search
Proteintech
MICU2 Polyclonal Antibody
{{$productOrderCtrl.translations['antibody.pdp.commerceCard.promotion.promotions']}}
{{$productOrderCtrl.translations['antibody.pdp.commerceCard.promotion.viewpromo']}}
{{$productOrderCtrl.translations['antibody.pdp.commerceCard.promotion.promocode']}}: {{promo.promoCode}} {{promo.promoTitle}} {{promo.promoDescription}}. {{$productOrderCtrl.translations['antibody.pdp.commerceCard.promotion.learnmore']}}
产品信息
20859-1-AP
种属反应
宿主/亚型
分类
类型
抗原
偶联物
形式
浓度
规格
纯化类型
保存液
内含物
保存条件
运输条件
产品详细信息
Immunogen sequence: QTAGCGSTFF RDLGDKGLIS YTEYLFLLTI LTKPHSGFHV AFKMLDTDGN EMIEKREFFK LQKIINKQDD LMTVKTNETG YQEAIVKEPE INTTLQMRFF GKRGQRKLHY KEFRRFMENL LTEIQEMEFL QFSKGLSFMR KEDFAEWLLF FTNTENKDIY WKNVREKLSA GESISLDEFK SFCHFTTHLE DFAIAMQMFS LAHRPVRLAE FKRAVKVATG QELSNNILDT VFKIFDLDGD ECLSHEEFLG VLKNRMHRGL WVPQHQSIQE YWKCVKKESI KGVKEVWKQA GKGLF
靶标信息
Key regulator of mitochondrial calcium uniporter (MCU) required to limit calcium uptake by MCU when cytoplasmic calcium is low. MICU1 and MICU2 form a disulfide-linked heterodimer that stimulate and inhibit MCU activity, depending on the concentration of calcium. MICU2 acts as a gatekeeper of MCU that senses calcium level via its EF-hand domains: prevents channel opening at resting calcium, avoiding energy dissipation and cell-death triggering.
仅用于科研。不用于诊断过程。未经明确授权不得转售。
篇参考文献 (0)
生物信息学
蛋白别名: Calcium uptake protein 2, mitochondrial; EF hand domain family A1; EF hand domain family, member A1; EF-hand domain-containing family member A1; hMICU3; Smhs2 homolog; unnamed protein product
基因别名: 1110008L20Rik; 4833427E09Rik; AU041871; EFHA1; hMICU3; MICU2; Smhs2
UniProt ID: (Human) Q8IYU8, (Mouse) Q8CD10
Entrez Gene ID: (Human) 221154, (Mouse) 68514